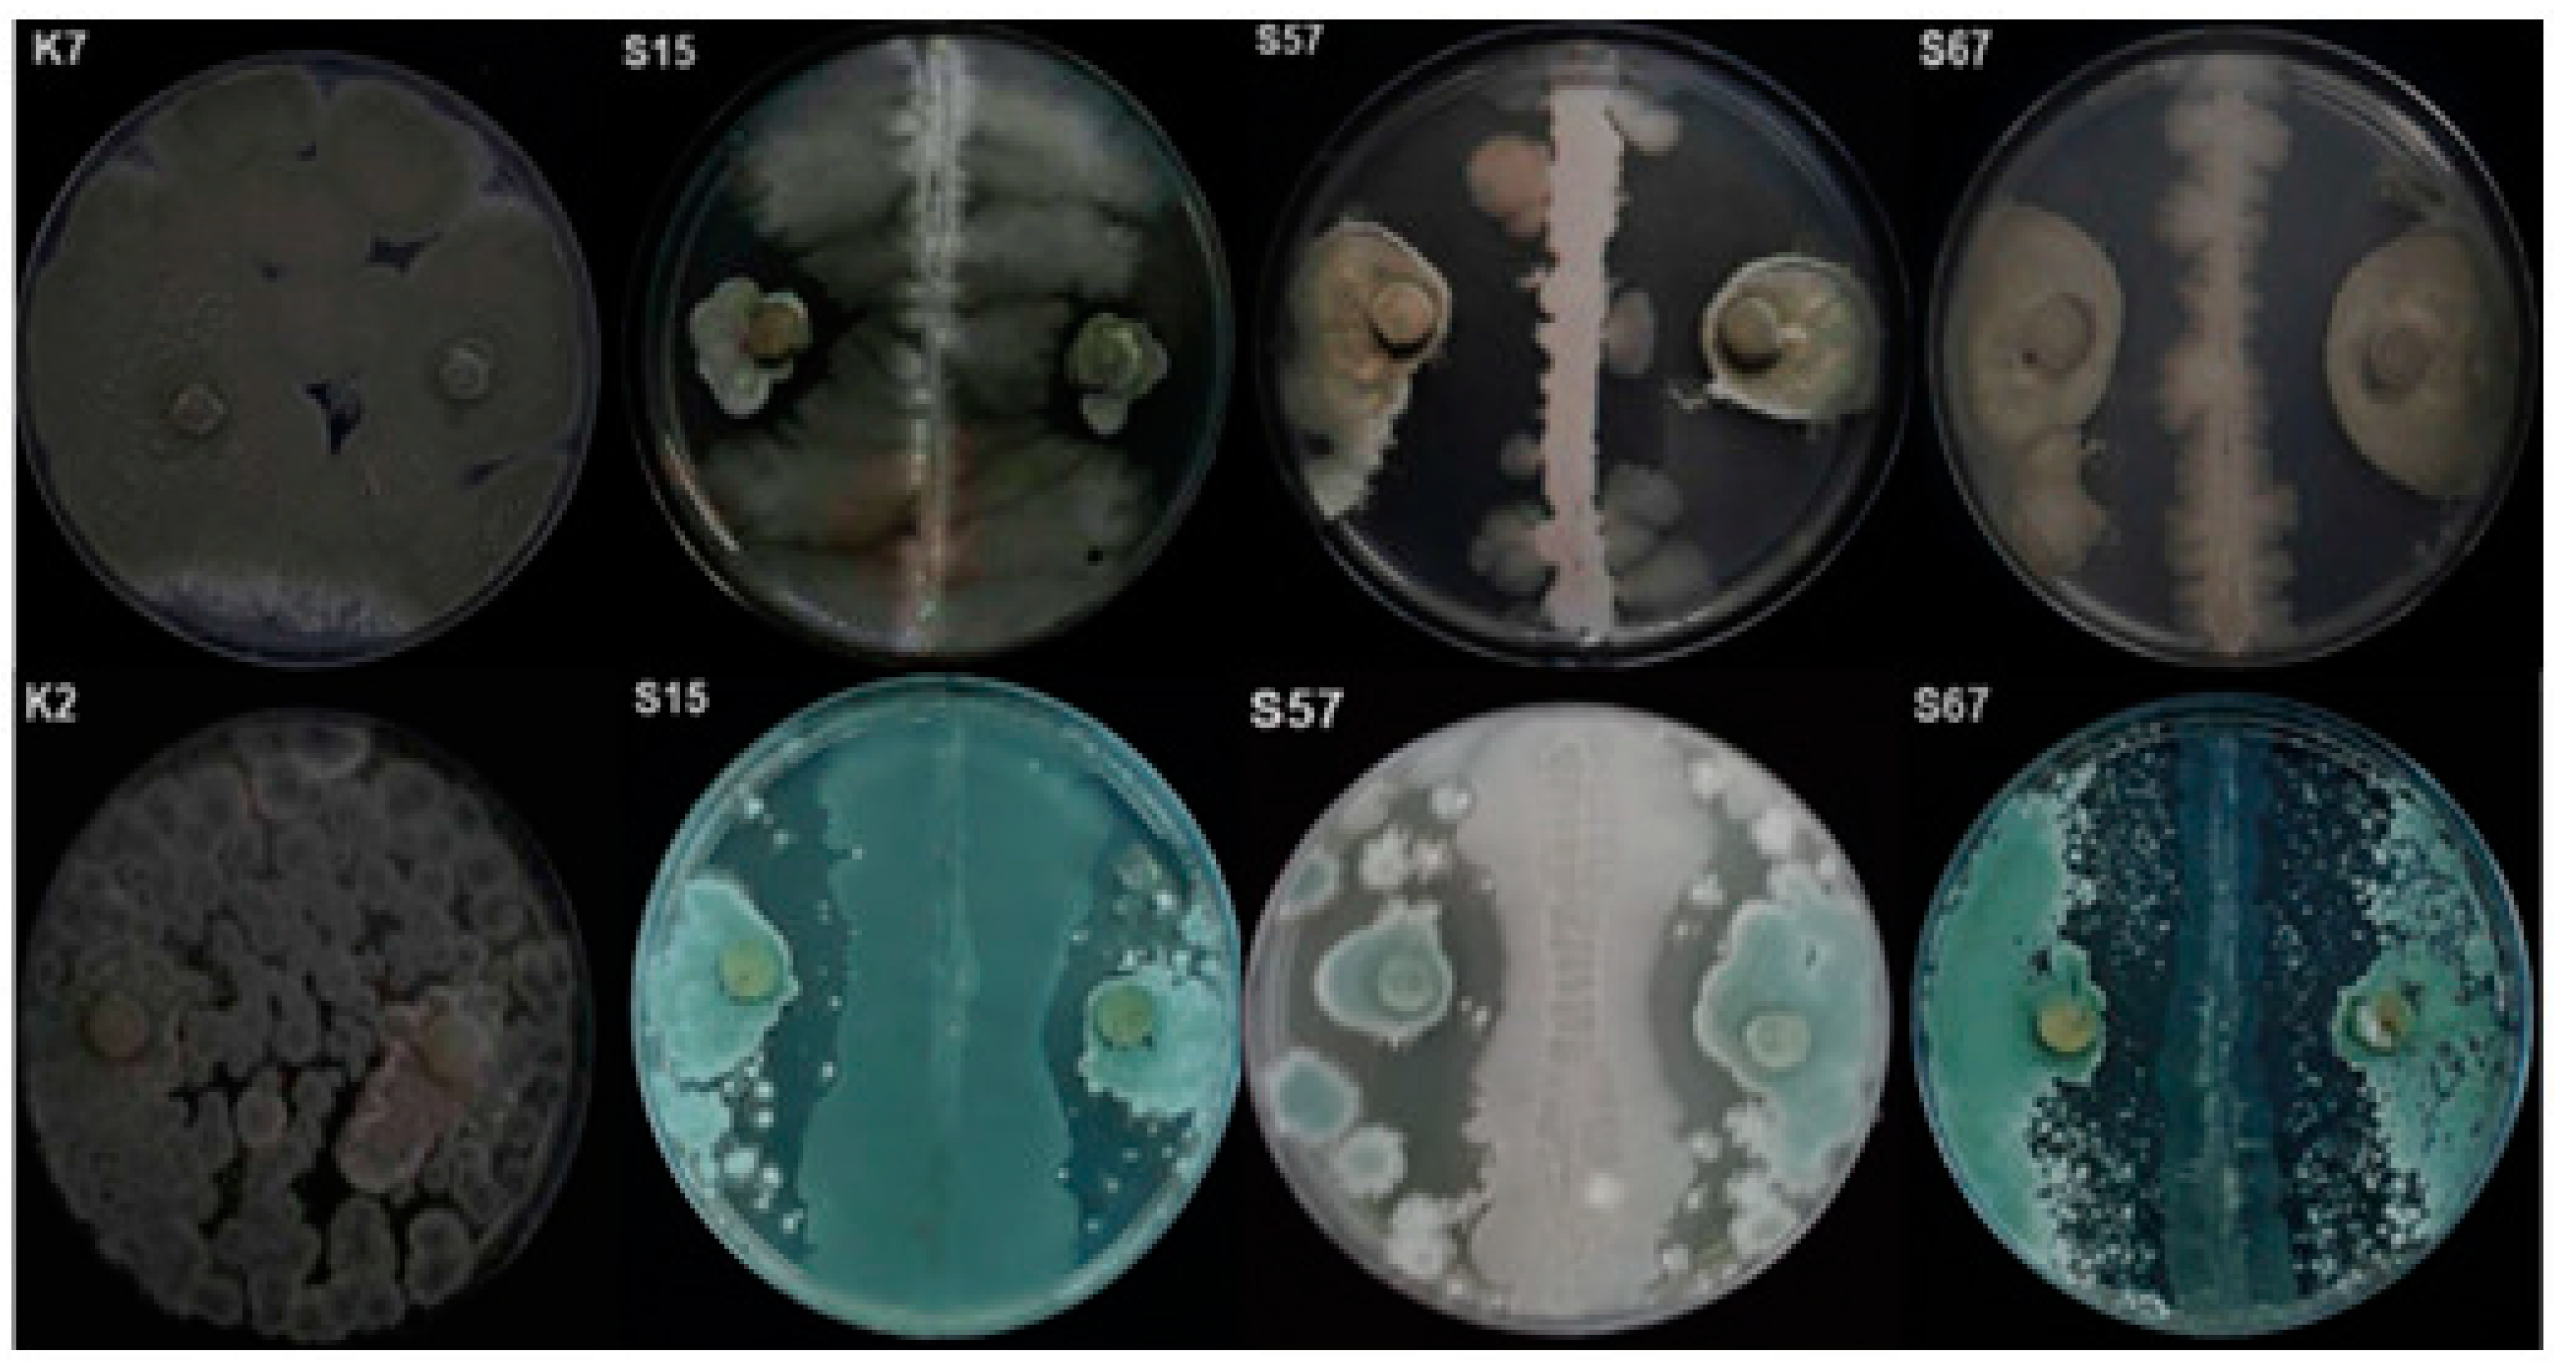
Jof 08 00818 g001

Epiphytic Yeasts and Bacteria as Candidate Biocontrol Agents of Green and Blue Molds of Citrus Fruits
Abstract
:1. Introduction
2. Materials and Methods
2.1. Citrus Fruits
2.2. Fungal Pathogens
2.3. Epiphytic Yeasts and Bacteria
2.4. In Vitro Screening of Isolates
2.5. Antagonistic Activity on Citrus Fruits
2.6. Molecular Identification of Yeast and Bacterial Isolates and Phylogenetic Tree Construction
2.7. Effectiveness of Isolates in Reducing Orange Fruit Decay
2.8. Effect of Treatments on Postharvest Quality of Oranges
2.9. Mechanisms of Action of Isolates Selected as Candidate BCAs
2.9.1. Hydrolytic Enzymatic Activity of Isolates Selected as Candidate BCAs
2.9.2. Ability of Isolates Selected as Candidate BCAs to Produce Volatile Organic Compounds
2.9.3. Biofilm Formation
2.9.4. PCR Detection of Genes Encoding for Antibiotic Biosynthesis
2.10. Statistical Analysis
3. Results
3.1. Screening of Microorganisms for In Vitro Antagonistic Activity
3.2. Bioassay on Citrus Fruits
3.3. Identification of Selected Microorganisms
3.4. Decay Due to Natural Infections
3.5. Hydrolytic Enzymes
3.6. Effect of VOCs Produced by Candidate BCAs
3.7. Biofilm Formation
3.8. Detection of Genes Encoding for Antibiotics
4. Discussion
5. Conclusions
Author Contributions
Funding
Institutional Review Board Statement
Informed Consent Statement
Data Availability Statement
Acknowledgments
Conflicts of Interest
References
- FAO. Citrus Fruit Statistical Compendium 2020. Rome. 2021. Available online: https://www.fao.org/publications/card/fr/c/CB6492EN/ (accessed on 8 June 2022).
- Albertini, M.V.; Carcouet, E.; Pailly, O.; Gambotti, C.; Luro, F.; Berti, L. Changes in organic acids and sugars during early stages of development of acidic and acidless citrus fruit. Agric. Food Chem. 2006, 54, 8335–8339. [Google Scholar] [CrossRef] [PubMed]
- Li, Q.L.; Ning, P.; Zheng, L.; Huang, J.B.; Li, G.Q.; Hsiang, T. Fumigant activity of volatiles of Streptomyces globisporus JK-1 against Penicillium italicum on Citrus microcarpa. Postharvest Biol. Technol. 2010, 58, 157–165. [Google Scholar] [CrossRef]
- Baldwin, E.A.; Bai, J.; Plotto, A.; Ritenour, M.A. Citrus fruit quality assessment; producer and consumer perspectives. Stewart Postharvest Rev. 2014, 10, 408. [Google Scholar]
- Ismail, M.; Zhang, J. Post-harvest citrus diseases and their control. Outlooks Pest. Manag. 2004, 15, 29–35. [Google Scholar] [CrossRef]
- Askarne, L.; Boubaker, H.; Boudyach, E.H.; Aoumar, A. Use of food additives to control postharvest citrus blue mold disease. Atlas J. Biol. 2013, 2, 147–153. [Google Scholar] [CrossRef]
- Talibi, I.; Boubaker, H.; Boudyach, E.H.; Ait, B.A.A. Alternative methods for the control of postharvest citrus diseases. J. Appl. Microbiol. 2014, 117, 1–17. [Google Scholar] [CrossRef]
- Youssef, K.; Sanzani, S.M.; Ligorio, A.; Ippolito, A.; Terry, L.A. Sodium carbonate and bicarbonate treatments induce resistance to postharvest green mould on citrus fruit. Postharvest Biol. Technol. 2014, 87, 61–69. [Google Scholar] [CrossRef]
- Perez, M.F.; Ibarreche, J.P.; Isas, A.S.; Sepulveda, M.; Ramallo, J.; Dib, J.R. Antagonistic yeasts for the biological control of Penicillium digitatum on lemons stored under export conditions. Biol. Control 2017, 115, 135–140. [Google Scholar] [CrossRef]
- Schirra, M.; D’Aquino, S.; Palma, A.; Marceddu, S.; Angioni, A.; Cabras, P.; Scherm, B.; Migheli, Q. Residue level, persistence, and storage performances of citrus fruit treated with fludioxonil. J. Agric. Food Chem. 2005, 53, 6718–6724. [Google Scholar] [CrossRef]
- D’Aquino, S.; Schirra, M.; Palma, A.; Angioni, A.; Cabras, P.; Migheli, Q. Residue levels and effectiveness of pyrimethanil vs. imazalil when using heated postharvest dip treatments for control of Penicillium decay on citrus fruit. J. Agric. Food Chem. 2006, 54, 4721–4726. [Google Scholar] [CrossRef]
- Smilanick, J.L.; Mansour, M.F.; Mlikota-Gabler, F.; Goodwine, W.R. The effectiveness of pyrimethanil to inhibit germination of Penicilliium digitatum and to control citrus green mold after harvest. Postharvest Biol. Technol. 2006, 42, 75–85. [Google Scholar] [CrossRef]
- Kanetis, L.; Förster, H.; Adaskaveg, J.E. Comparative efficacy of the new postharvest fungicides azoxystrobin, fludioxonil, and pyrimethanilfor managing citrus green mold. Plant Dis. 2007, 91, 1502–1511. [Google Scholar] [CrossRef] [PubMed] [Green Version]
- Boubaker, H.; Saadi, B.; Boudyach, E.H.; Benaoumar, A.A. Sensitivity of Penicillium digitatum and P. italicum to imazalil and thianbendazole in Morocco. Plant Pathol. 2009, 8, 152–158. [Google Scholar] [CrossRef] [Green Version]
- La Spada, F.; Aloi, F.; Coniglione, M.; Pane, A.; Cacciola, S.O. Natural biostimulants elicit plant immune system in an integrated management strategy of the postharvest green mold of orange fruits incited by Penicillium digitatum. Front. Plant Sci. 2021, 12, 1149. [Google Scholar] [CrossRef]
- Bhatta, U.K. Alternative management approaches of citrus diseases caused by Penicillium digitatum (Green Mold) and Penicillium italicum (Blue Mold). Front. Plant Sci. 2022, 12, 833328. [Google Scholar] [CrossRef] [PubMed]
- Sànchez-Torres, P.; Tuset, J.J. Molecular insights into fungicide resistance in sensitive and resistant Penicillium digitatum strains infecting citrus. Postharvest Biol. Technol. 2011, 59, 159–165. [Google Scholar] [CrossRef]
- Usall, J.; Ippolito, A.; Sisquella, M.; Neri, F. Physical treatments to control postharvest diseases of fresh fruits and vegetables. Postharvest Biol. Technol. 2016, 122, 30–40. [Google Scholar] [CrossRef]
- Stracquadanio, C.; Quiles, J.M.; Meca, G.; Cacciola, S.O. Antifungal activity of bioactive metabolites produced by Trichoderma asperellum and Trichoderma atroviride in liquid medium. J. Fungi 2020, 6, 263. [Google Scholar] [CrossRef]
- El boumlasy, S.; La Spada, F.; Tuccitto, N.; Marletta, G.; Mínguez, C.L.; Meca, G.; Rovetto, E.I.; Pane, A.; Debdoubi, A.; Cacciola, S.O. Inhibitory activity of shrimp waste extracts on fungal and oomycete plant pathogens. Plants 2021, 10, 2452. [Google Scholar] [CrossRef] [PubMed]
- Stracquadanio, C.; Luz, C.; La Spada, F.; Meca, G.; Cacciola, S.O. Inhibition of mycotoxigenic fungi in different vegetable matrices by extracts of Trichoderma species. J. Fungi 2021, 7, 445. [Google Scholar] [CrossRef]
- Camele, I.; Elshafie, H.S.; Caputo, L.; Sakr, S.H.; De Feo, V. Bacillus mojavensis: Biofilm formation and biochemical investigation of its bioactive metabolites. J. Biol. Res. 2019, 92, 39–45. [Google Scholar] [CrossRef]
- Elshafie, H.S.; Caputo, L.; De Martino, L.; Gruľová, D.; Zheljazkov, V.Z.; De Feo, V.; Camele, I. Biological investigations of essential oils extracted from three Juniperus species and evaluation of their antimicrobial, antioxidant and cytotoxic activities. J. Appl. Microbiol. 2020, 129, 1261–1271. [Google Scholar] [CrossRef] [PubMed]
- Nunes, C.A. Biological control of postharvest diseases of fruit. Eur. J. Plant Pathol. 2012, 133, 181–196. [Google Scholar] [CrossRef]
- Moraes Bazioli, J.M.; Belinato, J.R.; Costa, J.H.; Akiyama, D.Y.; de Pontes, J.G.M.; Kupper, K.C.; Augusto, F.; de Carvalho, J.E.; Fill, T.P. Biological control of citrus postharvest phytopathogens. Toxins 2019, 11, 460. [Google Scholar] [CrossRef] [Green Version]
- Wallace, R.L.; Hirkala, D.L.; Nelson, L.M. Mechanisms of action of three isolates of Pseudomonas fluorescens active against postharvest grey mold decay of apple during commercial storage. Biol. Control 2018, 117, 13–20. [Google Scholar] [CrossRef]
- Liu, J.; Sui, Y.; Wisniewski, M.; Droby, S.; Liu, Y. A review, Utilization of antagonistic yeasts to manage postharvest fungal disease control. Int. J. Food Microbiol. 2013, 167, 153–160. [Google Scholar] [CrossRef]
- Parafati, L.; Vitale, A.; Restuccia, C.; Cirvilleri, G. Biocontrol ability and action mechanism of food-isolated yeast strains against Botrytis cinerea causing postharvest bunch rot of table grape. Food Microbiol. 2015, 47, 85–92. [Google Scholar] [CrossRef]
- Spadaro, D.; Droby, S. Development of biocontrol products for postharvest diseases of fruit: The importance of elucidating the mechanisms of action of yeast antagonists. Trends Food Sci. Technol. 2016, 47, 39–49. [Google Scholar] [CrossRef]
- Sharma, R.R.; Singh, D.; Singh, R. Biological control of postharvest diseases of fruits and vegetables by microbial antagonists. Biol. Control 2009, 50, 205–221. [Google Scholar] [CrossRef]
- Liu, Y.; Wang, W.; Zhou, Y.; Yao, S.; Deng, L.; Zeng, K. Isolation, identification and in vitro screening of Chongqing orangery yeasts for the biocontrol of Penicillium digitatum on citrus fruit. Biol. Control 2017, 110, 18–24. [Google Scholar] [CrossRef]
- Liu, Y.; Yaoa, S.; Denga, L.; Minga, J.; Zenga, K. Different mechanisms of action of isolated epiphytic yeasts against Penicillium digitatum and Penicillium italicum on citrus fruit. Postharvest Biol. Technol. 2019, 152, 100–110. [Google Scholar] [CrossRef]
- El-Ghaouth, A.; Smilanick, J.L.; Wisniewski, M.; Wilson, C.L. Improved control of apple and citrus fruit decay with a combination of Candida saitoana and 2-deoxy-D-glucose. Plant Dis. 2000, 84, 249–253. [Google Scholar] [CrossRef] [PubMed] [Green Version]
- Hernandez-Montiel, L.G.; Ochoa, J.L.; Troyo-Diéguez, E.; Larralde-Corona, C.P. Biocontrol of postharvest blue mold (Penicillium italicum Wehmer) on Mexican lime by marine and citrus Debaryomyces hansenii isolates. Postharvest Biol. Technol. 2010, 56, 181–187. [Google Scholar] [CrossRef]
- Cengiz, C.; Füsun, B.U. Purification, characterization and in vivo biocontrol efficiency of killer toxins from Debaryomyces hansenii strains. Int. J. Biol. Macromol. 2018, 119, 1077–1082. [Google Scholar]
- Liu, P.; Luo, L.; Long, C. Characterization of competition for nutrients in the biocontrol of Penicillium italicum by Kloeckera apiculate. Biol. Control 2013, 67, 157–162. [Google Scholar] [CrossRef]
- Kinay, P.; Yildiz, M. The shelf life and effectiveness of granular formulations of Metschnikowia pulcherrima and Pichia guilliermondii yeast isolates that control postharvest decay of citrus fruit. Biol. Control 2008, 45, 433–440. [Google Scholar] [CrossRef]
- Zhang, H.Y.; Zheng, X.D.; Fu, C.X.; Xi, Y.F. Postharvest biological control of gray mold rot of pear with Cryptococcus laurentii. Postharvest Biol. Technol. 2005, 35, 79–86. [Google Scholar] [CrossRef]
- Zhang, H.Y.; Zheng, X.D.; Xi, Y.F. Biological control of postharvest blue mould of oranges by Cryptococcus laurentii (Kufferath) Skinner. BioControl 2005, 50, 331–342. [Google Scholar] [CrossRef]
- Parafati, L.; Cirvilleri, G.; Restuccia, C.; Wisniewski, M. Potential role of exoglucanase genes (waexg1 and waexg2) in the biocontrol activity Wickerhamomyces anomalus. Microb. Ecol. 2016, 73, 876–884. [Google Scholar] [CrossRef]
- Abraha, O.A.; Laing, M.D.; Bower, J.P. Isolation and in vivo screening of yeast and Bacillus antagonists for the control of Penicillium digitatum of citrus fruit. Biol. Control 2010, 53, 32–38. [Google Scholar] [CrossRef]
- Lahlali, R.; Raffaele, B.; Jijakli, M.H. UV protectants for Candida oleophila (strain O), a biocontrol agent of postharvest fruit diseases. Plant Pathol. 2011, 60, 288–295. [Google Scholar] [CrossRef]
- Chen, O.; Yi, L.; Deng, L.; Ruan, C.; Zeng, K. Screening antagonistic yeasts against citrus green mold and the possible biocontrol mechanisms of Pichia galeiformis (BAF03). J. Sci. Food Agric. 2020, 100, 3812–3821. [Google Scholar] [CrossRef] [PubMed]
- Zhou, Y.H.; Ming, J.; Deng, L.L.; Zeng, K.F. Effect of Pichia membranaefaciens in combination with salicylic acid on postharvest blue and green mold decay in citrus fruits. BioControl 2014, 74, 21–29. [Google Scholar] [CrossRef]
- Ferrz, L.P.; Cunha, T.; Silva, A.L.; Kupper, K.C. Biocontrol ability and putative mode of action of yeasts against Geotrichum citri-aurantii in citrus fruit. Microbiol. Res. 2016, 188, 72–79. [Google Scholar] [CrossRef] [PubMed]
- Zheng, X.D.; Zhang, H.Y.; Sun, P. Biological control of postharvest green mold decay on oranges by Rhodotorula glutinis. Eur. Food Res. 2005, 220, 353–357. [Google Scholar] [CrossRef]
- Li, W.H.; Zhang, H.Y.; Li, P.X.; Apaliya, M.T.; Yang, Q.Y.; Peng, Y.P.; Zhang, X.Y. Biocontrol of postharvest green mold of oranges by Hanseniaspora uvarum, Y3 in combination with phosphatidylcholine. Biol. Control 2016, 103, 30–38. [Google Scholar] [CrossRef]
- Leelasuphakul, W.; Hemmanee, P.; Chuenchitt, S. Growth inhibitory properties of Bacillus subtilis strains and their metabolites against the green mold pathogen (Penicillium digitatum Sacc.) of citrus fruit. Postharvest Biol. Technol. 2008, 48, 113–121. [Google Scholar] [CrossRef]
- Rodrigues, L.B.; Santos, L.R.D.; Tagliari, V.Z.; Rizzo, N.N.; Trenhago, G.; Oliveira, A.P.D.; Goetz, F.; Nascimento, V.P.D. Quantification of biofilm production on polystyrene by Listeria, Escherichia coli and Staphylococcus aureus isolated from a poultry slaughterhouse. Braz. J. Microbiol. 2010, 41, 1082–1085. [Google Scholar] [CrossRef] [Green Version]
- Waewthongrak, W.; Pisuchpen, S.; Leelasuphakul, W. Effect of Bacillus subtilis and chitosan applications on green mold (Penicilium digitatum Sacc.) decay in citrus fruit. Postharvest Biol. Technol. 2015, 99, 44–49. [Google Scholar] [CrossRef]
- Ambrico, A.; Trupo, M. Efficacy of cell free supernatant from Bacillus subtilis ET-1, an Iturin A producer strain, on biocontrol of green and gray mold. Postharvest Biol. Technol. 2017, 134, 5–10. [Google Scholar] [CrossRef]
- Mohammadi, P.; Tozlu, E.; Kotan, R.; Kotan Şenol, M. Potential of some bacteria for biological control of postharvest citrus green mould caused by Penicillium digitatum. Plant Prot. Sci. 2017, 53, 134–143. [Google Scholar]
- Lai, K.P.; Chen, S.H.; Hu, M.Y. Control of postharvest green mold of citrus fruit by application of endophytic Paenibacillus polymyxa strain SG-6. Postharvest Biol. Technol. 2012, 69, 40–48. [Google Scholar] [CrossRef]
- Calvo, H.; Marco, P.; Blanco, D.; Oria, R.; Venturini, M.E. Potential of a new strain of Bacillus amyloliquefaciens BUZ-14 as a biocontrol agent of postharvest fruit diseases. Int. J. Food Microbiol. 2017, 63, 101–110. [Google Scholar] [CrossRef] [PubMed] [Green Version]
- Chen, K.; Tian, Z.; Luo, Y.; Cheng, Y.; Long, C. Antagonistic activity and the mechanism of Bacillus amyloliquefaciens DH-4 against citrus green mold. Phytopathology 2018, 108, 1253–1262. [Google Scholar] [CrossRef] [PubMed] [Green Version]
- Jin, P.; Wang, H.; Tan, Z.; Xuan, Z.; Dahar, G.Y.; Li, Q.X.; Miao, W.; Liu, W. Antifungal mechanism of bacillomycin D from Bacillus velezensis HN-2 against Colletotrichum gloeosporioides Penz. Pestic. Biochem. Physiol. 2020, 163, 102–107. [Google Scholar] [CrossRef]
- Piggot, P.J.; Hilbert, D.W. Sporulation of Bacillus subtilis. Curr. Opin. Microbiol. 2004, 7, 579–586. [Google Scholar] [CrossRef]
- Romero, D.; Pérez-García, A.; Rivera, M.E.; Cazorla, F.M.; de Vicente, A. Isolation and evaluation of antagonistic bacteria towards the cucurbit powdery mildew fungus Podosphaera fusca. Appl. Microbiol. Biotechnol. 2004, 64, 263–269. [Google Scholar] [CrossRef]
- Torres, M.J.; Pérez Brandan, C.; Sabaté, D.C.; Petroselli, G.; Erra-Balsells, R.; Audisio, M.C. Biological activity of the lipopeptide-producing Bacillus amyloliquefaciens PGPBacCA1 on common bean Phaseolus vulgaris L. pathogens. Biol. Control 2017, 105, 93–99. [Google Scholar] [CrossRef]
- Ongena, M.; Jacques, P. Bacillus lipopeptides: Versatile weapons for plant disease biocontrol. Trends Microbiol. 2008, 16, 115–125. [Google Scholar] [CrossRef]
- Dewi, R.T.K.; Mubarik, N.R.; Suhartono, M.T. Medium optimization of β-glucanase production by Bacillus subtilis SAHA 32.6 used as biological control of oil palm pathogen. Emir. J. Food Agric. 2016, 116–125. [Google Scholar] [CrossRef] [Green Version]
- Li, X.; Zhang, Y.; Wei, Z.; Guan, Z.; Cai, Y.; Liao, X. Antifungal activity of isolated Bacillus amyloliquefaciens SYBC H47 for the biocontrol of peach gummosis. PLoS ONE 2016, 11, e0162125. [Google Scholar] [CrossRef] [PubMed] [Green Version]
- Chalutz, E.; Wilson, C.L. Postharvest biocontrol of green and blue mold and sour rot of citrus fruit by Debaryomyces hansenii. Plant Dis. 1990, 74, 134–137. [Google Scholar] [CrossRef]
- Urrea, R.; Cabezas, L.; Sierra, R.; Cárdenas, M.; Restrepo, S.; Jiménez, P. Selection of antagonistic bacteria isolated from the Physalis peruviana rhizosphere against Fusarium oxysporum. J. Appl. Microbiol. 2011, 111, 707–716. [Google Scholar] [CrossRef] [PubMed]
- Whipps, J.M. Effect of media on growth and interactions between a range of soil-borne glasshouse pathogens and antagonistic fungi. New Phytol. 1987, 107, 127–142. [Google Scholar] [CrossRef]
- Sadfi-Zouaoui, N.; Essghaier, B.; Hajlaoui, M.R.; Fardeau, M.L.; Cayaol, J.L.; Ollivier, B.; Boudabous, A. Ability of moderately halophilic bacteria to control grey mould disease on tomato fruits. J. Phytopathol. 2008, 156, 42–52. [Google Scholar] [CrossRef]
- Lima, I.R.; Gondim, D.M.F.; Oliveria, F.S.A.; Goncalves, L.R.B.; Viana, F.M.P. Use of killer yeasts in the management of postharvest papaya anthracnose. Postharvest Biol. Technol. 2013, 83, 58–64. [Google Scholar] [CrossRef]
- White, T.J.; Bruns, T.; Lee, S.; Taylor, J. Amplification and direct sequencing of fungal ribosomal RNA genes for phylogenetics. In PCR Protocols: A Guide to Methods and Applications; Innis, M.A., Gelfand, D.H., Sninsky, J.J., White, T.J., Eds.; Academic Press Inc.: New York, NY, USA, 1990; Volume 18, pp. 315–321. [Google Scholar]
- El Arbi, A.; Rochex, A.; Chataigné, G.; Béchet, M.; Lecouturier, D.; Arnauld, S.; Gharsallah, N.; Jacques, P. The Tunisian oasis ecosystem is a source of antagonistic Bacillus spp. producing diverse antifungal lipopeptides. Res. Microbiol. 2016, 167, 46–57. [Google Scholar] [CrossRef]
- Kumar, S.; Stecher, G.; Li, M.; Knyaz, C.; Tamura, K. MEGA X: Molecular evolutionary genetics analysis across computing platforms. Mol. Biol. Evol. 2018, 35, 1547. [Google Scholar] [CrossRef]
- Townsend, G.K.; Hunburger, T.W. Methods for estimating losses caused by diseases in fungicide experiments. Plant Dis. 1943, 27, 340–343. [Google Scholar]
- Milind, S.L. Citrus Fruit: Biology, Technology and Evaluation, 1st ed.; Elsevier Inc.: Atlanta, GA, USA, 2008; pp. 1–10. [Google Scholar]
- Cao, S.F.; Yuan, Y.G.; Hu, Z.C.; Zheng, Y.H. Combination of Pichia membranifaciens and ammonium molybdate for controlling blue mould caused by Penicillium expansum in peach fruit. Int. J. Food Microbiol. 2010, 141, 173–176. [Google Scholar] [CrossRef]
- Hao, W.N.; Li, H.; Hu, M.Y.; Yang, L.; Muhammad, R. Integrated control of citrus green and blue mold and sour rot by Bacillus amyloliquefaciens in combination with tea saponin. Postharvest Biol. Technol. 2011, 59, 316–323. [Google Scholar] [CrossRef]
- Sangwanich, S.; Sangchote, S.; Leelasuphakul, W. Biocontrol of citrus green mould and postharvest quality parameters. Int. Food Res. J. 2013, 20, 3381–3386. [Google Scholar]
- Teodoro, C.E.D.S.; Martins, M.L.L. Culture conditions for the production of thermostable amylase by Bacillus sp. Braz. J. Microbiol. 2000, 31, 298–302. [Google Scholar] [CrossRef]
- Kasana, R.C.; Salwan, R.; Dhar, H.; Dutt, S.; Gulati, A. A rapid and easy method for the detection of microbial cellulases on agar plates using gram’s iodine. Curr. Microbiol. 2008, 57, 503–507. [Google Scholar] [CrossRef]
- Buzzini, P.; Martini, A. Extracellular enzymatic activity profiles in yeast and yeast-like strains isolated from tropical environments. J. Appl. Microbiol. 2002, 93, 1020–1025. [Google Scholar] [CrossRef]
- Yin, L.J.; Tai, H.M.; Jiang, S.T. Characterization of mannanase from a novel mannanase-producing bacterium. Agric. Food Chem. 2012, 60, 6425–6431. [Google Scholar] [CrossRef]
- Singh, R.; Pandey, K.D.; Monika, S.; Kumar, A. PGPR isolates from the rhizosphere of vegetable crop Momordica charantia: Characterization and application as biofertilizer. Int. J. Curr. Microbiol. Appl. Sci. 2017, 6, 1789–1802. [Google Scholar]
- O’Toole, G.A. Microtiter dish biofilm formation assay. J. Vis. Exp. 2011, 47, 2437. [Google Scholar] [CrossRef]
- Ramarathnam, R. Mechanisms of Phyllosphere Biological Control of Leptosphaeria maculans, the Blackleg Pathogen of Canola, Using Antagonistic Bacteria. Ph.D. Thesis, Department of Plant Science, University of Manitoba, Winnipeg, MB, Canada, 2007. [Google Scholar]
- Arthur, T.; Marlène, C.I.; Bart, S.; Philippe, J. New approach for the detection of non ribosomal peptides synthetases of Bacillus strains by polymerase chain reaction. Appl. Microbiol. Biotechnol. 2010, 85, 1521–1531. [Google Scholar]
- Mora, I.; Cabrefiga, J.; Montesinos, E. Antimicrobial peptide genes in Bacillus strains from plant environments. Int. Microbiol. 2011, 14, 213–223. [Google Scholar]
- Khabbaz, S.E.; Zhang, L.; Cáceres, L.A.; Sumarah, M.; Wang, A.; Abbasi, P.A. Characterisation of antagonistic Bacillus and Pseudomonas strains for biocontrol potential and suppression of damping off and root rot diseases. Ann. Appl. 2015, 166, 456–471. [Google Scholar] [CrossRef]
- Vero, S.; Mondino, P.; Burgueno, J.; Soubes, M.; Wisniewski, M. Characterization of biological activity of two yeast strains from Uruguay against blue mold of apples. Postharvest Biol. Technol. 2002, 26, 91–98. [Google Scholar] [CrossRef]
- Bouzerda, L.; Boubaker, H.; Boudyach, E.; Akhayat, O.; Aoumar, A. Selection of antagonistic yeasts to green mold disease of citrus in Morocco. J. Food Agric. Environ. 2003, 1, 215–218. [Google Scholar]
- Brannen, P.M.; Kenney, D.S. Kodiak®—A successful biological-control product for suppression of soil-borne plant pathogens of cotton. J. Ind. Microbiol. Biotechnol. 1997, 19, 169–171. [Google Scholar] [CrossRef]
- Raspanti, E.; Cacciola, S.O.; Gotor, C.; Romero, L.C.; García, I. Implications of cysteine metabolism in the heavy metal response in Trichoderma harzianum and in three Fusarium species. Chemosphere 2009, 76, 48–54. [Google Scholar] [CrossRef]
- Puglisi, I.; Faedda, R.; Sanzaro, V.; Lo Piero, A.R.; Petrone, G.; Cacciola, S.O. Identification of differentially expressed genes in response to mercury I and II stress in Trichoderma harzianum. Gene 2012, 506, 325–330. [Google Scholar] [CrossRef]
- Caulier, S.; Gillis, A.; Colau, G.; Licciardi, F.; Liépin, M.; Desoignies, N.; Modrie, P.; Legrève, A.; Mahillon, J.; Bragard, C. Versatile antagonistic activities of soil-borne Bacillus spp. and Pseudomonas spp. against Phytophthora infestans and other potato pathogens. Front. Microbiol. 2018, 9, 143. [Google Scholar] [CrossRef]
- La Spada, F.; Stracquadanio, C.; Riolo, M.; Pane, A.; Cacciola, S.O. Trichoderma counteracts the challenge of Phytophthora nicotianae infections on tomato by modulating plant defense mechanisms and the expression of crinkler, necrosis-inducing Phytophthora protein 1, and cellulose-binding elicitor lectin pathogenic effectors. Front. Plant Sci. 2020, 11, 583539. [Google Scholar]
- Niu, B.; Wang, W.; Yuan, Z.; Sederoff, R.R.; Sederoff, H.; Chiang, V.L.; Borriss, R. Microbial interactions within multiple-strain biological control agents impact soil-borne plant diseases. Front. Microbiol. 2020, 11, 585404. [Google Scholar] [CrossRef]
- Deng, J.; Kong, S.; Wang, F.; Liu, Y.; Jiao, J.; Lu, Y.; Zhang, F.; Wu, J.; Wang, L.; Li, X. Identification of a new Bacillus sonorensis strain KLBC GS-3 as a biocontrol agent for postharvest green mould in grapefruit. Biol. Control 2020, 151, 104–393. [Google Scholar] [CrossRef]
- Lu, L.; Lu, H.; Wu, C.; Fang, W.; Yu, C.; Ye, C.; Shi, Y.; Yu, T.; Zheng, X. Rhodosporidium paludigenum induces resistance and defense-related responses against Penicillium digitatum in citrus fruit. Postharvest Biol. Technol. 2013, 85, 196–202. [Google Scholar] [CrossRef]
- Grzegorczyk, M.; Szalewicz, A.; Zarowska, B.; Połomska, X.; Watorek, W.; Wojtatowicz, M. Microorganisms in biological control of phytopathogenic fungi. Acta Sci. Agric. 2015, 14, 19–42. [Google Scholar]
- Pretorius, D.; Rooyen, J.V.; Clarke, K.G. Enhanced production of antifungal lipopeptides by Bacillus amyloliquefaciens for biocontrol of postharvest disease. New Biotechnol. 2015, 32, 243–252. [Google Scholar] [CrossRef] [PubMed]
- Yu, S.M.; Oh, B.T.; Lee, Y.H. Biocontrol of green and blue molds in postharvest satsuma mandarin using Bacillus amyloliquefaciens JBC36. Biocontrol Sci. Technol. 2012, 22, 1181–1197. [Google Scholar] [CrossRef]
- Droby, S.; Vinokur, V.; Weiss, B.; Cohen, L.; Daus, A.; Goldschmidt, E.E.; Porat, R. Induction of resistance to Penicillium digitatum in grapefruit by the yeast biocontrol agent Candida oleophila. Phytopathology 2002, 92, 393–399. [Google Scholar] [CrossRef] [Green Version]
- Ahimou, F.; Jacques, P.; Deleu, M. Surfactin and iturin A effects on Bacillus subtilis surface hydrophobicity. Enzyme Microb. Technol. 2000, 27, 749–754. [Google Scholar] [CrossRef]
- Stein, T. Bacillus subtilis antibiotics: Structures, syntheses and specific functions. Mol. Microbiol. 2005, 56, 845–857. [Google Scholar] [CrossRef]
- Hsieh, F.C.; Lin, T.C.; Meng, M.; Kao, S.S. Comparing methods for identifying Bacillus strains capable of producing the antifungal lipopeptide iturin A. Curr. Microbiol. 2008, 56, 1–5. [Google Scholar] [CrossRef]
- Arrebola, E.; Sivakumar, D.; Korsten, L. Effect of volatile compounds produced by Bacillus strains on postharvest decay in citrus. Biol. Control 2010, 53, 122–128. [Google Scholar] [CrossRef]
- Yoshida, S.; Hiradate, S.; Tsukamoto, T.; Hatakeda, K.; Shirata, A. Antimicrobial activity of culture filrate of Bacillus amyloliquefaciens RC-2isolated from mulberry leaves. Phytopathology 2001, 91, 181–187. [Google Scholar] [CrossRef] [Green Version]
- Yu, G.Y.; Sinclair, J.B.; Hartman, G.L.; Bertagnolli, B.L. Production of iturin A by Bacillus amyloliquefaciens suppressing Rhizoctonia solani. Soil Biol. Biochem. 2002, 34, 955–963. [Google Scholar] [CrossRef]
- Ma, X.; Wang, X.B.; Cheng, J.; Nie, X.; Yu, X.X.; Zhao, Y.T.; Wang, W. Microencapsulation of Bacillus subtilis B99-2 and its biocontrol efficiency against Rhizoctonia solani in tomato. Biol. Control 2015, 90, 34–41. [Google Scholar] [CrossRef]
- Chen, H.; Xiao, X.; Wang, J.; Wu, L.; Zheng, Z.; Yu, Z. Antagonistic effects of volatiles generated by Bacillus subtilis on spore germination and hyphal growth of the plant pathogen Botrytis cinerea. Biotechnol. Lett. 2008, 30, 919–923. [Google Scholar] [CrossRef] [PubMed]
- Senthil, R.; Prabakar, K.; Rajendran, L.; Karthikeyan, G. Efficacy of different biological control agents against major postharvest pathogens of grapes under room temperature storage conditions. Phytopathol. Mediterr. 2011, 50, 55–65. [Google Scholar]
- Casals, C.; Elmer, P.A.G.; Vinas, I.; Teixido, N.; Sisquella, M.; Usall, J. The combination of curing with either chitosan or Bacillus subtilis CPA-8 to control brown rot infections caused by Monlinia fructicola. Postharvest Biol. Technol. 2012, 64, 126–132. [Google Scholar] [CrossRef]
- Maachia, B.; Rafik, E.; Chérif, M.; Nandal, P.; Mohapatra, T.; Bernard, P. Biological control of the grapevine diseases ‘grey mold’ and ‘powdery mildew’ by Bacillus B27 and B29 strains. Indian J. Exp. Biol. 2015, 53, 109–115. [Google Scholar] [PubMed]
- Wang, F.; Xiao, J.; Zhang, Y.; Li, R.; Liu, L.; Deng, J. Biocontrol ability and action mechanism of Bacillus halotolerans against Botrytis cinerea causing grey mould in postharvest strawberry fruit. Postharvest Biol. Technol. 2021, 174, 111456. [Google Scholar] [CrossRef]
- Wang, S.L.; Yeh, P.Y. Purification and characterization of a chitosanase from a nattokinase producing strain Bacillus subtilis TKU007. Process Biochem. 2008, 43, 132–138. [Google Scholar] [CrossRef]
- Janisiewicz, W.J.; Korsten, L. Biological control of postharvest diseases of fruits. Annu. Rev. Phytopathol. 2002, 40, 411–441. [Google Scholar] [CrossRef] [Green Version]
- Chan, Z.L.; Tian, S.P. Interaction of antagonistic yeasts against post-harvest pathogens of apple fruit and possible mode of action. Postharvest Biol.Technol. 2005, 36, 215–223. [Google Scholar] [CrossRef]
- Droby, S.; Wisniewski, M.; Macarisinb, D.; Wilson, C. Twenty years of postharvest biocontrol research: Is it time for a new paradigm? Postharvest Biol. Technol. 2009, 52, 137–145. [Google Scholar] [CrossRef]
- Zhang, D.; Spadaro, D.; Garibaldi, A.; Gullino, M.L. Potential biocontrol activity of a strain of Pichia guilliermondii against grey mold of apples and its possible modes of action. Biol. Control 2011, 57, 193–201. [Google Scholar] [CrossRef]
- Banani, H.; Spadaro, D.; Zhang, D.; Matic, S.; Garibaldi, A.; Gullino, M.L. Biocontrol activity of an alkaline serine protease from Aureobasidium pullulans expressed in Pichia pastoris against four post-harvest pathogens on apple. Int. J. Food Microbiol. 2014, 18, 1–8. [Google Scholar] [CrossRef] [PubMed]
- Gao, H.; Li, P.; Xu, X.; Zeng, Q.; Guan, W. Research on volatile organic compounds from Bacillus subtilis CF-3: Biocontrol effects on fruit fungal pathogens and dynamic changes during fermentation. Front. Microbiol. 2018, 9, 456. [Google Scholar] [CrossRef] [PubMed]
- Bais, H.P.; Fall, R.; Vivanco, J.M. Biocontrol of Bacillus subtilis against infection of Arabidopsis roots by Pseudomonas syringae is facilitated by biofilm formation and surfactin production. Plant Physiol. 2004, 134, 307–319. [Google Scholar] [CrossRef] [PubMed] [Green Version]
- Khezri, M.; Ahmadzadeh, M.; Jouzani, G.S.; Behboudi, K.; Ahangaran, A.; Mousivand, M.; Rahimian, H. Characterization of some biofilm-forming Bacillus subtilis strains and evaluation of their biocontrol potential against Fusarium culmorum. J. Plant Pathol. 2011, 93, 373–382. [Google Scholar]
- Yang, W.; Yan, H.; Zhang, J.; Gao, Y.; Xu, W.; Shang, J.; Luo, Y. Inhibition of biofilm formation by Cd2+ on Bacillus subtilis 1JN2 depressed its biocontrol efficiency against Ralstonia wilt on tomato. Microbiol. Res. 2018, 215, 1–6. [Google Scholar] [CrossRef]
- da Cunha, T.; Ferraz, L.P.; Wher, P.P.; Kupper, K.C. Antifungal activity and action mechanisms of yeasts isolates from citrus against Penicillium italicum. Int. J. Food Microbiol. 2017, 276, 20–27. [Google Scholar] [CrossRef] [Green Version]
- Nally, M.C.; Pesce, V.M.; Maturano, Y.P.; Rodriguez Assaf, L.A.; Toro, M.E.; Vazquez, F. Antifungal modes of action of Saccharomyces and other biocontrol yeasts against fungi isolated from sour and grey rots. Int. J. Food Microbiol. 2015, 204, 91–100. [Google Scholar] [CrossRef]
- Parafati, L.; Vitale, A.; Restuccia, C.; Cirvilleri, G. Performance evaluation of volatile organic compounds by antagonistic yeasts immobilized on hydrogel spheres against gray, green and blue postharvest decays. Food Microbiol. 2017, 63, 191–198. [Google Scholar] [CrossRef]
- Tan, H.W.; Tay, S.T. Anti-Candida activity and biofilm inhibitory effects of secreted products of tropical environmental yeasts. Trop. Biomed. 2011, 28, 175–180. [Google Scholar] [PubMed]
- Platania, C.; Restuccia, C.; Muccilli, S.; Cirvilleri, G. Efficacy of killer yeasts in the biological control of Penicillium digitatum on Tarocco orange fruits (Citrus sinensis). Food Microbiol. 2012, 30, 219–225. [Google Scholar] [CrossRef]
- Aloui, H.; Licciardello, F.; Khwaldia, K.; Hamdi Restuccia, C. Physical properties and antifungal activity of bioactive films containing Wickerhamomyces anomalus killer yeast and their application for preservation of oranges and control of postharvest green mold caused by Penicillium digitatum. Int. J. Food Microbiol. 2015, 200, 22–30. [Google Scholar] [CrossRef] [PubMed]
- Naumov, G.; Naumova, E.S.; Lee, C.F. Towards reinstatement of the yeast genus Zygowilliopsis Kudriavzev (1960). Microbiology 2015, 84, 503–511. [Google Scholar] [CrossRef] [PubMed]
- Grzegorczyk, M.; Żarowska, B.; Restuccia, C.; Cirvilleri, G. Postharvest biocontrol ability of killer yeasts against Monilinia fructigena and Monilinia fructicola on stone fruit. Int. J. Food Microbiol. 2017, 61, 93–101. [Google Scholar] [CrossRef] [PubMed]
- Aladin, A.; Dib, J.R.; Malek, R.A.; Enshasy, H.A.E. Killer yeast, a novel biological control of soilborne diseases for good agriculture practice. In Sustainable Technologies for the Management of Agricultural Waste; Springer: Singapore, 2018; pp. 71–86. [Google Scholar]
- Mannaa, M.; Seo, Y.S. Plants under the attack of allies: Moving towards the plant pathobiome paradigm. Plants 2021, 10, 125. [Google Scholar] [CrossRef]
- Wilson, C.L.; Wisniewski, M.E.; Droby, S.; Chalutz, E.A. Selection strategy for microbial antagonists to control postharvest diseases of fruits and vegetables. Sci. Hortic. 1993, 53, 183–189. [Google Scholar] [CrossRef]
- Pangallo, S.; Li Destri Nicosia, M.G.; Raphael, G.; Levin, E.; Ballistreri, G.; Cacciola, S.O.; Rapisarda, P.; Droby, S.; Schena, L. Elicitation of resistance responses in grapefruit and lemon fruits treated with a pomegranate peel extract. Plant Pathol. 2017, 66, 633–640. [Google Scholar] [CrossRef]
- Belgacem, I.; Pangallo, S.; Abdelfattah, A.; Romeo, F.V.; Cacciola, S.O.; Li Destri Nicosia, M.G.; Ballistreri, G.; Schena, L. Transcriptomic analysis of orange fruit treated with pomegranate peel extract (PGE). Plants 2019, 8, 101. [Google Scholar] [CrossRef] [Green Version]
- Minchev, Z.; Konstenko, O.; Soler, R.; Pozo, M.J. Microbial consortia for the effective biocontrol of root and foliar diseases in tomato. Front. Plant Sci. 2021, 12, 756368. [Google Scholar] [CrossRef]

| Isolates | P. digitatum K7 Mycelial Growth Inhibition (%) | P. italicum K2 Mycelial Growth Inhibition (%) |
|---|---|---|
| Bacillus amyloliquefaciens S15 | 76 ± 2 a | 45 ± 2 b |
| B. subtilis S57 | 60 ± 0 b | 73 ± 2 a |
| B. pumilus S67 | 60 ± 0 b | 32 ± 7 c |
| Candida oleophila L12 | 32 ± 5 c | 20 ± 6 c |
| Debaryomyces hansenii L16 | 28 ± 5 c | 20 ± 6 c |
| Treatment ab | Weight Loss (%) | Fruit Firmness Variation (%) | TSSs Variation (%) | TA Variation (%) | Ascorbic Acid Variation (%) |
|---|---|---|---|---|---|
| S57 | 22.63 a | 49.27 bc | 5.05 g | 31.82 b | 2.90 a |
| IMZ | 24.14 b | 29.200 ab | 1.56 f | 40.37 d | 7.40 d |
| S15 | 25.98 c | 29.03 ab | −4.66 a | 36.62 c | 3.65 b |
| L12 | 26.80 d | 11.57 a | 0.30 c | 77.03 g | 2.72 a |
| S67 | 27.36 d | 33.61 ab | 0.45 e | 45.53 e | 3.84 b |
| L16 | 29.19 e | 61.71 c | 0 b | 0.72 a | 2.90 a |
| Control | 30.43 f | 31.19 ab | 0.33 d | 61.73 f | 4.76 c |
| Strains | Enzymatic Activity | ||||||
|---|---|---|---|---|---|---|---|
| Mananase | Amylase | Protease | Cellulase | Chitinase | Pectinase | Urease | |
| S15 | + | + | + | + | + | + | - |
| S57 | + | + | + | + | - | + | - |
| S67 | + | - | + | - | - | - | - |
| L12 | + | - | - | + | - | - | - |
| L16 | + | - | - | + | - | + | - |
| Isolates | % Reduction of P. digitatum K7 Colony Diameter | % Reduction of P. italicum K2 Colony Diameter |
|---|---|---|
| Bacillus amyloliquefaciens S15 | 61 ± 0.01 a | 54 ± 0.00 a |
| B. subtilis S57 | 60 ± 0.00 a | 51 ± 0.05 a |
| B. pumilus S67 | 47 ± 0.02 b | 51 ± 0.01 a |
| Debaryomyces hansenii L16 | 41 ± 0.01 c | 6 ± 0.00 c |
| Candida oleophila L12 | 7 ± 0.05 d | 41 ± 0.01 b |
| Isolates | Optical Density (OD) |
|---|---|
| Bacillus amyloliquefaciens S15 | 0.20 ± 0.35 c |
| B. subtilis S57 | 0.26 ± 0.39 c |
| B. pumilus S67 | 0.29 ± 0.00 c |
| Candida oleophila L12 | 0.91 ± 0.28 a |
| Debaryomyces hansenii L16 | 0.75 ± 0.24 b |
Publisher’s Note: MDPI stays neutral with regard to jurisdictional claims in published maps and institutional affiliations. |
© 2022 by the authors. Licensee MDPI, Basel, Switzerland. This article is an open access article distributed under the terms and conditions of the Creative Commons Attribution (CC BY) license (https://creativecommons.org/licenses/by/4.0/).
Share and Cite
Hammami, R.; Oueslati, M.; Smiri, M.; Nefzi, S.; Ruissi, M.; Comitini, F.; Romanazzi, G.; Cacciola, S.O.; Sadfi Zouaoui, N. Epiphytic Yeasts and Bacteria as Candidate Biocontrol Agents of Green and Blue Molds of Citrus Fruits. J. Fungi 2022, 8, 818. https://doi.org/10.3390/jof8080818
Hammami R, Oueslati M, Smiri M, Nefzi S, Ruissi M, Comitini F, Romanazzi G, Cacciola SO, Sadfi Zouaoui N. Epiphytic Yeasts and Bacteria as Candidate Biocontrol Agents of Green and Blue Molds of Citrus Fruits. Journal of Fungi. 2022; 8(8):818. https://doi.org/10.3390/jof8080818
Chicago/Turabian StyleHammami, Rania, Maroua Oueslati, Marwa Smiri, Souhaila Nefzi, Mustapha Ruissi, Francesca Comitini, Gianfranco Romanazzi, Santa Olga Cacciola, and Najla Sadfi Zouaoui. 2022. "Epiphytic Yeasts and Bacteria as Candidate Biocontrol Agents of Green and Blue Molds of Citrus Fruits" Journal of Fungi 8, no. 8: 818. https://doi.org/10.3390/jof8080818
APA StyleHammami, R., Oueslati, M., Smiri, M., Nefzi, S., Ruissi, M., Comitini, F., Romanazzi, G., Cacciola, S. O., & Sadfi Zouaoui, N. (2022). Epiphytic Yeasts and Bacteria as Candidate Biocontrol Agents of Green and Blue Molds of Citrus Fruits. Journal of Fungi, 8(8), 818. https://doi.org/10.3390/jof8080818









